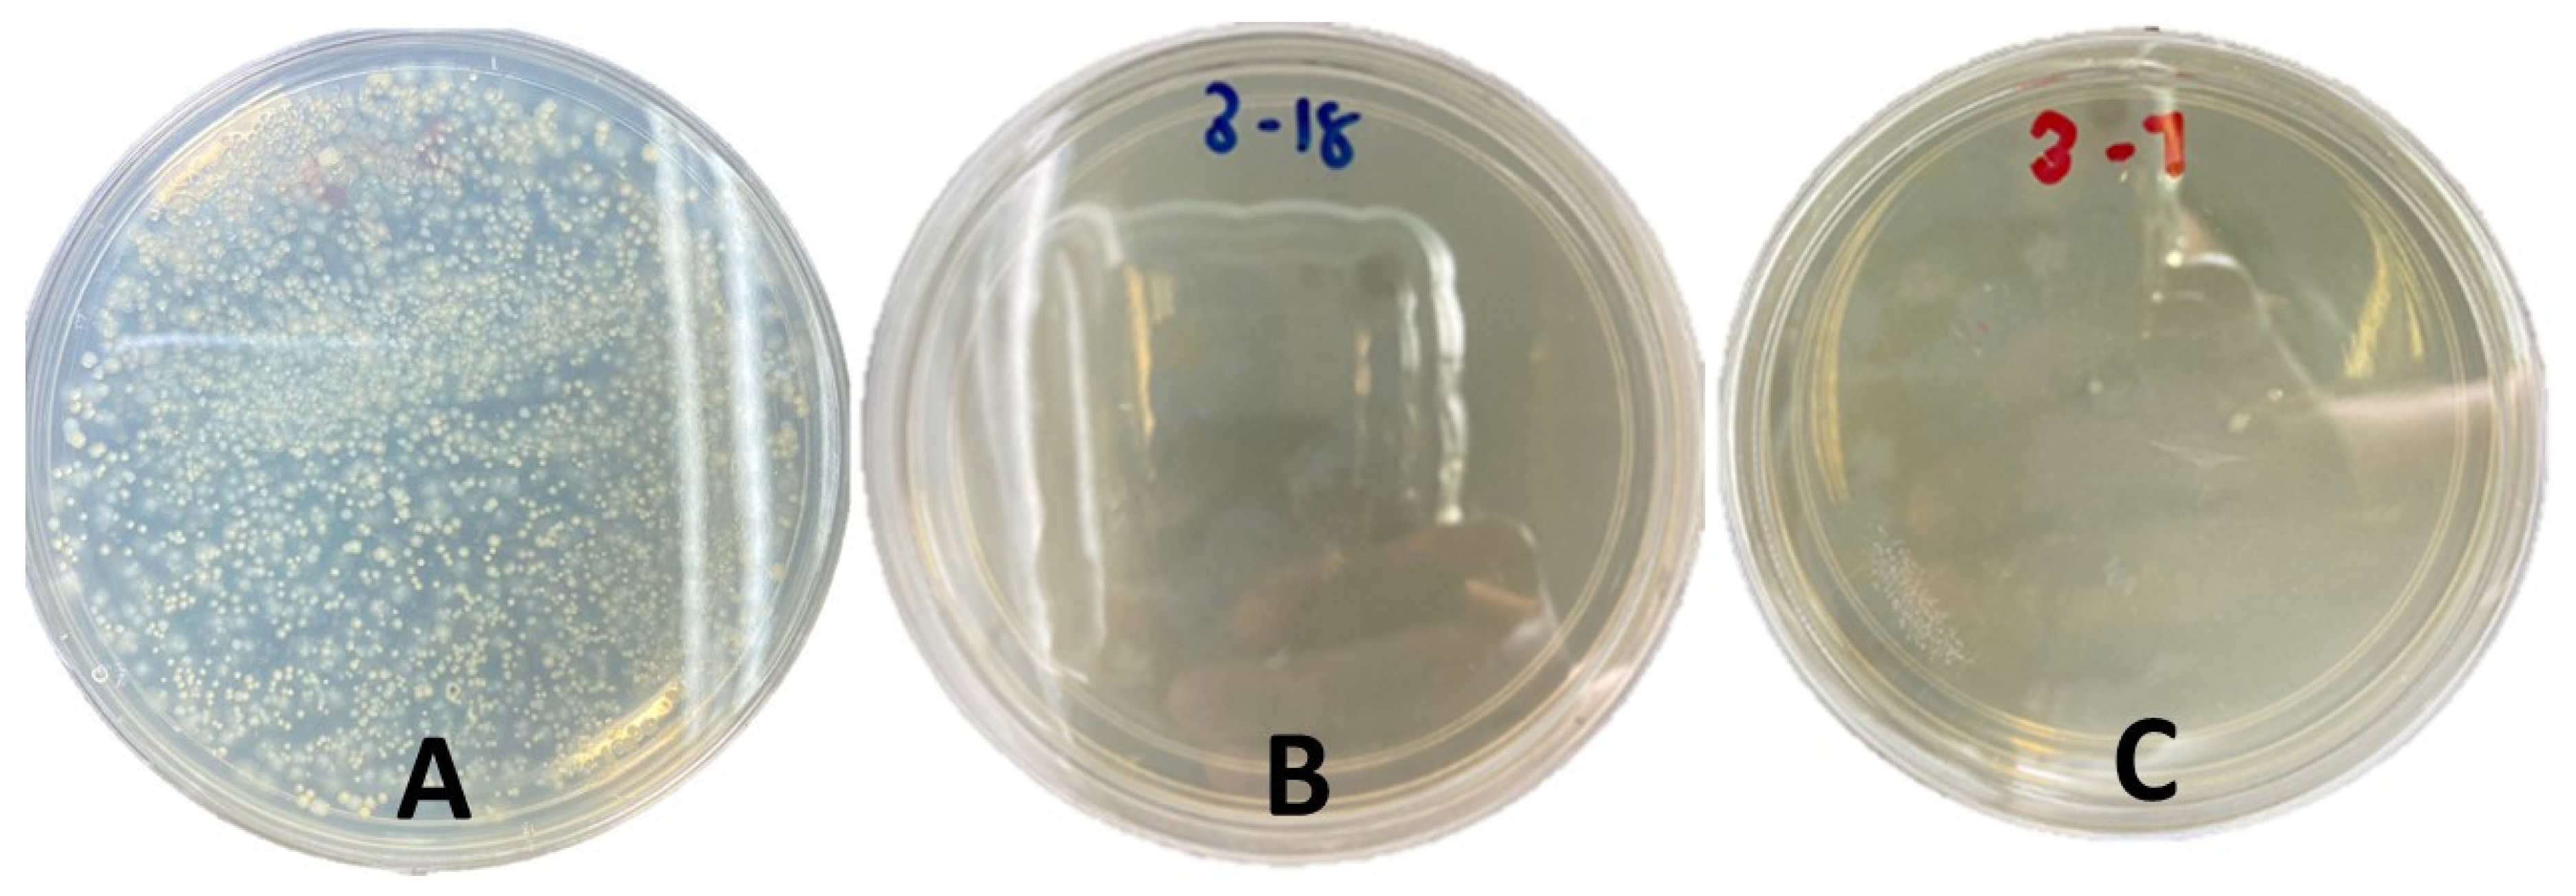
Water 15 01172 g014 Water 15 01172 g014

Decolourisation of Real Industrial and Synthetic Textile Dye Wastewater Using Activated Dolomite
Abstract
1. Introduction
2. Materials and Methods
2.1. Activation of Dolomite
2.2. Preparation of Textile Dye Wastewater
2.3. Experimental Treatment
2.4. Morphological Analysis
2.5. Removal of Colour, COD and Adsorption Study
2.6. Kinetics Study
2.7. Bacterial Assay
3. Results
3.1. Physical and Morphological Observation
3.2. Optimisation of RTDW Decolourisation
3.3. Optimisation of STDW Decolourisation
3.4. Effect of Activation Temperature
3.4.1. Colour Percentage Removal
3.4.2. COD Percentage Reduction
3.5. Effect of Adsorbent Size
3.5.1. Colour Percentage Removal
3.5.2. COD Percentage Reduction
3.6. Effect of Adsorbent Concentration
3.6.1. Colour Percentage Removal
3.6.2. COD Percentage Reduction
3.7. Adsorption Isotherms
3.7.1. Study of Adsorption Model
3.7.2. Study on Adsorption Kinetics
3.8. Antimicrobial Properties
3.9. Comparison of Current Work on Adsorption Using Activated Dolomite with Other Types of Adsorbents
3.10. Limitations, Challenges and Future Strategy of Dolomite Decolourisation
- High Energy Consumption
- Cost Efficiency
- Sustainable Resources
- Treatment Stability
- Waste Management
4. Discussion
5. Conclusions
Author Contributions
Funding
Data Availability Statement
Acknowledgments
Conflicts of Interest
References
- Pang, Y.L.; Abdullah, A.Z. Current Status of Textile Industry Wastewater Management and Research Progress in Malaysia: A Review. Clean—Soil Air Water 2013, 41, 751–764. [Google Scholar] [CrossRef]
- Abdullahi, S.S.; Musa, H.; Habibu, S.; Birniwa, A.H.; Mohammad, R.E.A. Facile Synthesis and Dyeing Performance of Some Disperse Monomeric and Polymeric Dyes on Nylon and Polyester Fabrics. Bull. Chem. Soc. Ethiop. 2021, 35, 485–497. [Google Scholar] [CrossRef]
- Ventura, B.D.C.C.; Marin, M.A.M. Azo Dyes: Characterisation and Toxicity—A Review. Text. Light Ind. Sci. Technol. 2013, 2, 85–103. [Google Scholar]
- Namasivayam, C.; Yamuna, R.T. Removal of congo red from aqueous solutions by biogas waste slurry. J. Chem. Technol. Biotechnol. 1992, 53, 153–157. [Google Scholar] [CrossRef]
- Hafidz, I.F.M.; Ramli, M.S.; Abdullah, N.R.; Wan-Mohtar, W.A.A.Q.I.; Azizan, N.H.; Sharif, F. Decolorization potential of bacteria isolated from Sungai Lembing hot springs and Ganoderma lucidum on methyl red dye. AIP Conf. Proc. 2022, 2454, 050027. [Google Scholar] [CrossRef]
- Hanafiah, Z.M.; Wan Mohtar, W.H.M.; Hasan, H.A.; Jensen, H.S.; Klaus, A.; Sharil, S.; Wan-Mohtar, W.A.A.Q.I. Ability of Ganoderma lucidum mycelial pellets to remove ammonia and organic matter from domestic wastewater. Int. J. Environ. Sci. Technol. 2022, 19, 7307–7320. [Google Scholar] [CrossRef]
- Mooralitharan, S.; Mohd Hanafiah, Z.; Abd Manan, T.S.B.; Muhammad-Sukki, F.; Wan-Mohtar, W.A.A.Q.I.; Wan Mohtar, W.H.M. Vital Conditions to Remove Pollutants from Synthetic Wastewater Using Malaysian Ganoderma lucidum. Sustainability 2023, 15, 3819. [Google Scholar] [CrossRef]
- Wagner, M.; Eicheler, C.; Helmreich, B.; Hilbig, H.; Heinz, D. Removal of Congo Red From Aqueous Solutions at Hardened Cement Paste Surfaces. Front. Mater. 2020, 7, 567130. [Google Scholar] [CrossRef]
- Ghaly, A.E.; Ananthashankar, R.; Alhattab, M.V.V.R.; Ramakrishnan, V.V. Production, Characterisation and Treatment of Textile Effluents: A Critical Review. J. Chem. Eng. Process Technol. 2014, 5, 1000182. [Google Scholar] [CrossRef]
- Crini, G.; Lichtfouse, E. Advantages and disadvantages of techniques used for wastewater treatment. Environ. Chem. Lett. 2019, 17, 145–155. [Google Scholar] [CrossRef]
- Cai, L.; Zhang, Y.; Zhou, Y.; Zhang, X.; Ji, L.; Song, W.; Zhang, H.; Liu, J. Effective Adsorption of Diesel Oil by Crab-Shell-Derived Biochar Nanomaterials. Materials 2019, 12, 236. [Google Scholar] [CrossRef] [PubMed]
- Ariffin, N.; Mustafa, M.; Bakri, A.; Remy, M.; Mohd, R.; Zaino, A.; Murshed, M.F.; Faris, M.A. Review on Adsorption of Heavy Metal in Wastewater by Using Geopolymer. MATEC Web Conf. 2017, 97, 01023. [Google Scholar] [CrossRef]
- Shaaban, M.; Peng, Q.A.; Hu, R.; Wu, Y.; Lin, S.; Zhao, J. Dolomite application to acidic soils: A promising option for mitigating N2O emissions. Environ. Sci. Pollut. Res. 2015, 22, 19961–19970. [Google Scholar] [CrossRef]
- Kim, M.J.; Hong, S.H.; Lee, J.I.; Lee, C.G.; Park, S.J. Removal of fluoride from water using thermally treated dolomite and optimisation of experimental conditions using response surface methodology. Desalination Water Treat. 2019, 155, 311–320. [Google Scholar] [CrossRef]
- Hui, P.X.; Ramkumar, M.; Nagarajan, R.; Mathew, M.J.; Ng, T.F. Episodic dolomitisation of Paleozoic limestones in the Kinta Valley, Malaysia: Implications on porosity evolution and reservoir properties. Energy Geosci. 2021, 2, 298–307. [Google Scholar] [CrossRef]
- Salleh, M.N.; Kasim, H.; Ismail, K.N.; Mohd, C.; Ghazali, R.; Saad, S.A.; Daud, S. Characterisation and Application of Dolomite Rock in Perlis. In Proceedings of the 1st International Conference on Natural Resources Engineering & Technology, Putrajaya, Malaysia, 24–25 July 2006; pp. 465–470. [Google Scholar]
- Mohammed, M.A.A.; Salmiaton, A.; Wan Azlina, W.A.K.G.; Mohamad Amran, M.S.; Taufiq-Yap, Y.H. Preparation and Characterisation of Malaysian Dolomites as a Tar Cracking Catalyst in Biomass Gasification Process. J. Energy 2013, 2013, 791582. [Google Scholar] [CrossRef]
- Ghaemi, A.; Torab-Mostaedi, M.; Ghannadi-Maragheh, M. Characterisations of strontium(II) and barium(II) adsorption from aqueous solutions using dolomite powder. J. Hazard. Mater. 2011, 190, 916–921. [Google Scholar] [CrossRef] [PubMed]
- Ghaemi, A.; Torab-Mostaedi, M.; Shahhosseini, S.; Asadollahzadeh, M. Characterisation of Ag(I), Co(II) and Cu(II) removal process from aqueous solutions using dolomite powder. Korean J. Chem. Eng. 2013, 30, 172–180. [Google Scholar] [CrossRef]
- Yan, S.; Wang, Q.; Liu, J.; Huo, W.; Yang, J.; Huang, Y. Synthesis, Characterisation and Adsorption Properties of Low-cost Porous Calcined Dolomite Microspheres for Removal of Dyes. J. Wuhan Univ. Technol.-Mater. Sci. Ed. 2019, 34, 507–515. [Google Scholar] [CrossRef]
- Han, R.; Zou, L.; Zhao, X.; Xu, Y.; Xu, F.; Li, Y.; Wang, Y. Characterisation and properties of iron oxide-coated zeolite as adsorbent for removal of copper(II) from solution in fixed bed column. Chem. Eng. J. 2009, 149, 123–131. [Google Scholar] [CrossRef]
- Khoshraftar, Z.; Masoumi, H.; Ghaemi, A. An insight into the potential of dolomite powder as a sorbent in the elimination of heavy metals: A review. Case Stud. Chem. Environ. Eng. 2023, 7, 100276. [Google Scholar] [CrossRef]
- McKelvy, M.J.; Chizmeshya, A.V.; Squires, K.; Carpenter, R.W.; Béarat, H. A Novel Approach to Mineral Carbonation: Enhancing Carbonation While Avoiding Mineral Pretreatment Process Cost; Arizona State University: Tempe, AZ, USA, 2006. [Google Scholar] [CrossRef]
- Ziane, S.; Bessaha, F.; Marouf-Khelifa, K.; Khelifa, A. Single and binary adsorption of reactive black 5 and Congo red on modified dolomite: Performance and mechanism. J. Mol. Liq. 2018, 249, 1245–1253. [Google Scholar] [CrossRef]
- Ayawei, N.; Ebelegi, A.N.; Wankasi, D. Modelling and Interpretation of Adsorption Isotherms. J. Chem. 2017, 2017, 3039817. [Google Scholar] [CrossRef]
- Ebelegi, A.N.; Ayawei, N.; Wankasi, D. Interpretation of Adsorption Thermodynamics and Kinetics. Open J. Phys. Chem. 2020, 10, 166–182. [Google Scholar] [CrossRef]
- Ho, Y.S. Citation review of Lagergren kinetic rate equation on adsorption reactions. Scientometrics 2004, 59, 171–177. [Google Scholar] [CrossRef]
- Pouretedal, H.R.; Kazemi, M. Characterisation of modified silica aerogel using sodium silicate precursor and its application as adsorbent of Cu2+, Cd2+, and Pb2+ ions. Int. J. Ind. Chem. 2012, 3, 20. [Google Scholar] [CrossRef]
- Birniwa, A.H.; Mahmud, H.N.M.E.; Abdullahi, S.S.; Habibu, S.; Jagaba, A.H.; Ibrahim, M.N.M.; Ahmad, A.; Alshammari, M.B.; Parveen, T.; Umar, K. Adsorption Behavior of Methylene Blue Cationic Dye in Aqueous Solution Using Polypyrrole-Polyethylenimine Nano-Adsorbent. Polymers 2022, 14, 3362. [Google Scholar] [CrossRef]
- Khalilzadeh Shirazi, E.; Metzger, J.W.; Fischer, K.; Hassani, A.H. Removal of textile dyes from single and binary component systems by Persian bentonite and a mixed adsorbent of bentonite/charred dolomite. Colloids Surf. A Physicochem. Eng. Asp. 2020, 598, 124807. [Google Scholar] [CrossRef]
- Calugaru, I.L.; Neculita, C.M.; Genty, T.; Bussière, B.; Potvin, R. Performance of thermally activated dolomite for the treatment of Ni and Zn in contaminated neutral drainage. J. Hazard. Mater. 2016, 310, 48–55. [Google Scholar] [CrossRef]
- Walker, G.M.; Hansen, L.; Hanna, J.A.; Allen, S.J. Kinetics of a reactive dye adsorption onto dolomitic sorbents. Water Res. 2003, 37, 2081–2089. [Google Scholar] [CrossRef]
- Kutty, S.R.M.; Almahbashi, N.M.Y.; Nazrin, A.A.M.; Malek, M.A.; Noor, A.; Baloo, L.; Ghaleb, A.A.S. Adsorption kinetics of colour removal from palm oil mill effluent using wastewater sludge carbon in column studies. Heliyon 2019, 5, e02439. [Google Scholar] [CrossRef]
- Li, J.; Hitch, M. Mechanical activation of magnesium silicates for mineral carbonation, a review. Miner. Eng. 2018, 128, 69–83. [Google Scholar] [CrossRef]
- Viegas, R.M.C.; Mesquita, E.; Campinas, M.; Rosa, M.J. Pilot studies and cost analysis of hybrid powdered activated carbon/ceramic microfiltration for controlling pharmaceutical compounds and organic matter in water reclamation. Water 2020, 12, 33. [Google Scholar] [CrossRef]
- Kumar Shukla, S.; Said Al Mushaiqri, N.R.; Al Subhi, H.M.; Yoo, K.; Al Sadeq, H. Low-cost activated carbon production from organic waste and its utilisation for wastewater treatment. Appl. Water Sci. 2020, 10, 62. [Google Scholar] [CrossRef]
- Ivanets, A.I.; Kitikova, N.V.; Shashkova, I.L.; Oleksiienko, O.V.; Levchuk, I.; Sillanpää, M. Using of phosphatised dolomite for treatment of real mine water from metal ions. J. Water Process Eng. 2016, 9, 246–253. [Google Scholar] [CrossRef]
- Piol, M.N.; Paricoto, M.; Saralegui, A.B.; Basack, S.; Vullo, D.; Boeykens, S.P. Dolomite used in phosphate water treatment: Desorption processes, recovery, reuse and final disposition. J. Environ. Manag. 2019, 237, 359–364. [Google Scholar] [CrossRef]
- Rat’Ko, A.I.; Ivanets, A.I.; Kulak, A.I.; Morozov, E.A.; Sakhar, I.O. Thermal decomposition of natural dolomite. Inorg. Mater. 2011, 47, 1372–1377. [Google Scholar] [CrossRef]
- Salameh, Y.; Albadarin, A.B.; Allen, S.; Walker, G.; Ahmad, M.N.M. Arsenic(III,V) adsorption onto charred dolomite: Charring optimisation and batch studies. Chem. Eng. J. 2015, 259, 663–671. [Google Scholar] [CrossRef]
- Mastalerz, M.; Schimmelmann, A.; Drobniak, A.; Chen, Y. Porosity of Devonian and Mississippian New Albany Shale across a maturation gradient: Insights from organic petrology’, gas adsorption, and mercury intrusion. AAPG Bull. 2013, 97, 1621–1643. [Google Scholar] [CrossRef]
- Ugwu, E.I.; Tursunov, O.; Kodirov, D.; Shaker, L.M.; Al-Amiery, A.A.; Yangibaeva, I.; Shavkarov, F. Adsorption mechanisms for heavy metal removal using low cost adsorbents: A review. IOP Conf. Ser. Earth Environ. Sci. 2020, 614, 012166. [Google Scholar] [CrossRef]
- Jung, S.J.; Park, S.Y.; Kim, S.E.; Kang, I.; Park, J.; Lee, J.; Kim, C.M.; Chung, M.S.; Ha, S.D. Bactericidal Effect of Calcium Oxide (Scallop-Shell Powder) Against Pseudomonas aeruginosa Biofilm on Quail Egg Shell, Stainless Steel, Plastic, and Rubber. J. Food Sci. 2017, 82, 1682–1687. [Google Scholar] [CrossRef] [PubMed]

| Raw Dolomite (Weight %) | Activated Dolomite (Weight %) | Treated Activated Dolomite (Weight %) | |||
|---|---|---|---|---|---|
| O | 33.47 | O | 41.17 | O | 42.27 |
| Ca | 38.73 | Ca | 24.13 | Ca | 27.6 |
| C | 6.7 | C | 16.13 | C | 13.93 |
| Mg | 21.13 | Mg | 14.4 | Mg | 14.3 |
| Fe | 1.8 | Fe | 1.8 | ||
| Ti | 0.9 | Ti | 0.8 | ||
| Mn | 1.2 | Mn | 0.6 | ||
| Si | 0.2 | Si | 0.2 | ||
| Al | 0.1 | Al | 0.1 | ||
| Source | Sum of Squares | df | Mean Square | F-Value | p-Value | |
|---|---|---|---|---|---|---|
| Model | 6881.22 | 9 | 764.58 | 8.14 | 0.0015 | significant |
| A-Temperature | 3707.01 | 1 | 3707.01 | 39.47 | <0.0001 | |
| B-Size | 77.91 | 1 | 77.91 | 0.8295 | 0.3839 | |
| C-Weight | 397.72 | 1 | 397.72 | 4.23 | 0.0666 | |
| AB | 44.25 | 1 | 44.25 | 0.4711 | 0.5081 | |
| AC | 26.26 | 1 | 26.26 | 0.2796 | 0.6085 | |
| BC | 258.05 | 1 | 258.05 | 2.75 | 0.1284 | |
| A2 | 708.70 | 1 | 708.70 | 7.54 | 0.0206 | |
| B2 | 38.29 | 1 | 38.29 | 0.4076 | 0.5375 | |
| C2 | 2.29 | 1 | 2.29 | 0.0244 | 0.8791 | |
| Residual | 939.31 | 10 | 93.93 | |||
| Lack of Fit | 277.84 | 5 | 55.57 | 0.4200 | 0.8185 | not significant |
| Pure Error | 661.47 | 5 | 132.29 | |||
| Cor Total | 7820.53 | 19 | ||||
| Std. Dev. | 9.69 | R2 | 0.8799 | Adeq. Precision | 9.8000 | |
| Mean | 67.79 | Adjusted R2 | 0.7718 | |||
| C.V. % | 14.30 | Predicted R2 | 0.6945 |
| Source | Sum of Squares | df | Mean Square | F-Value | p-Value | |
|---|---|---|---|---|---|---|
| Model | 3917.47 | 9 | 435.27 | 7.75 | 0.0018 | significant |
| A-Temperature | 2625.57 | 1 | 2625.57 | 46.74 | <0.0001 | |
| B-Size | 54.77 | 1 | 54.77 | 0.9750 | 0.3467 | |
| C-Weight | 147.05 | 1 | 147.05 | 2.62 | 0.1367 | |
| AB | 1.51 | 1 | 1.51 | 0.0269 | 0.8730 | |
| AC | 145.66 | 1 | 145.66 | 2.59 | 0.1384 | |
| BC | 31.39 | 1 | 31.39 | 0.5588 | 0.4720 | |
| A2 | 66.73 | 1 | 66.73 | 1.19 | 0.3013 | |
| B2 | 73.08 | 1 | 73.08 | 1.30 | 0.2806 | |
| C2 | 6.25 | 1 | 6.25 | 0.1113 | 0.7455 | |
| Residual | 561.72 | 10 | 56.17 | |||
| Lack of Fit | 198.98 | 5 | 39.80 | 0.5486 | 0.7371 | not significant |
| Pure Error | 362.74 | 5 | 72.55 | |||
| Cor Total | 4479.19 | 19 | ||||
| Std. Dev. | 7.49 | R2 | 0.8746 | Adeq. Precision | 8.4772 | |
| Mean | 56.43 | Adjusted R2 | 0.7617 | |||
| C.V. % | 13.28 | Predicted R2 | 0.5625 |
| Adsorbates | Langmuir Isotherm | Freundlich Isotherm | ||||
|---|---|---|---|---|---|---|
| qm (mg/g) | KL (L/mg) | R2 | KF | n | R2 | |
| STDW | 0.3482 | 0.0203 | 0.9484 | 338.49 | −0.3253 | 0.9383 |
| RTDW | 0.3519 | 0.8490 | 0.9686 | 1.0603 | −1.8501 | 0.9493 |
| Adsorbates | qexp (mg/g) | Pseudo-First-Order | Pseudo-Second-Order | ||||
|---|---|---|---|---|---|---|---|
| K1 (min−1) | qe (mg/g) | R2 | K2 (g/mg·min) | qe (mg/g) | R2 | ||
| STDW | 2.60 | 0.0044 | 6.0076 | 0.5685 | 0.00537 | 4.1946 | 0.5137 |
| RTDW | 0.80 | 0.0221 | 0.8984 | 0.9879 | 0.07475 | 0.8719 | 0.9592 |
| Type of Adsorbents | Compound Removed | Activation Temperature | Retention Time | COD Reduction | Colour Reduction | Microbial Reduction | Ref. |
|---|---|---|---|---|---|---|---|
| Activated Dolomite | Textile andMethyl Orange | 300 °C, 700 °C, 900 °C | 2 h | 66.70%, 73.95% | 98.70%, 78.0% | Yes | This study |
| Activated dolomite | Reactive Black 5 and Congo Red | 900 °C | 2 h | NA | 80.46% | NA | [24] |
| Polypyrrole-Polyethyleneimine | Methylene Blue | 65 °C | 24 h | NA | 99% | NA | [29] |
| Mixture of bentonite and charred dolomite | Basic Violet 16, Reactive Red 195 | 800 °C | 20 min | NA | >50% | NA | [30] |
| Activated dolomite | Orange I | 900 °C | 2 h | NA | 18.40% | NA | [31] |
| Activated sludge plants | Colour from Treated Palm Oil Mill Effluents | 700 °C | 1 h | NA | 90–95% | NA | [33] |
Disclaimer/Publisher’s Note: The statements, opinions and data contained in all publications are solely those of the individual author(s) and contributor(s) and not of MDPI and/or the editor(s). MDPI and/or the editor(s) disclaim responsibility for any injury to people or property resulting from any ideas, methods, instructions or products referred to in the content. |
© 2023 by the authors. Licensee MDPI, Basel, Switzerland. This article is an open access article distributed under the terms and conditions of the Creative Commons Attribution (CC BY) license (https://creativecommons.org/licenses/by/4.0/).
Share and Cite
Zahuri, A.A.; Abdul Patah, M.F.; Kamarulzaman, Y.; Hashim, N.H.; Thirumoorthi, T.; Wan Mohtar, W.H.M.; Mohd Hanafiah, Z.; Amir, Z.; Wan-Mohtar, W.A.A.Q.I. Decolourisation of Real Industrial and Synthetic Textile Dye Wastewater Using Activated Dolomite. Water 2023, 15, 1172. https://doi.org/10.3390/w15061172
Zahuri AA, Abdul Patah MF, Kamarulzaman Y, Hashim NH, Thirumoorthi T, Wan Mohtar WHM, Mohd Hanafiah Z, Amir Z, Wan-Mohtar WAAQI. Decolourisation of Real Industrial and Synthetic Textile Dye Wastewater Using Activated Dolomite. Water. 2023; 15(6):1172. https://doi.org/10.3390/w15061172
Chicago/Turabian StyleZahuri, Afnan Ahmadi, Muhamad Fazly Abdul Patah, Yusniza Kamarulzaman, Nor Hazlina Hashim, Thinaranjeney Thirumoorthi, Wan Hanna Melini Wan Mohtar, Zarimah Mohd Hanafiah, Zulhelmi Amir, and Wan Abd Al Qadr Imad Wan-Mohtar. 2023. "Decolourisation of Real Industrial and Synthetic Textile Dye Wastewater Using Activated Dolomite" Water 15, no. 6: 1172. https://doi.org/10.3390/w15061172
APA StyleZahuri, A. A., Abdul Patah, M. F., Kamarulzaman, Y., Hashim, N. H., Thirumoorthi, T., Wan Mohtar, W. H. M., Mohd Hanafiah, Z., Amir, Z., & Wan-Mohtar, W. A. A. Q. I. (2023). Decolourisation of Real Industrial and Synthetic Textile Dye Wastewater Using Activated Dolomite. Water, 15(6), 1172. https://doi.org/10.3390/w15061172

